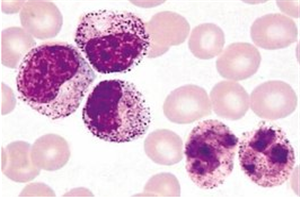

靶向药百科
*以上解读内容仅供参考,癌症123不对解读内容负责。
易瑞沙(吉非替尼)对肺癌骨转移有效吗?
2018-04-16易瑞沙(吉非替尼)适用于治疗既往接受过化学治疗的局部晚期或转移性非小细胞肺癌(NSCLC)的患者。既往化学治疗主要是指铂剂和多西紫杉醇治疗。本品对于既往接受过化学治
易瑞沙的耐药机制是怎样的?
2018-04-16易瑞沙的主要成分是吉非替尼,是由英国阿斯利康研发生产的抗肺癌靶向药品,主要适用于治疗既往接受过化学治疗的局部晚期或者已经出现转移的非小细胞肺癌的患者。本品推荐
易瑞沙耐药后吃中药效果如何?
2018-04-16易瑞沙是一种新型的小分子量肿瘤治疗药物,其作用机制主要是通过抑制EGFR自身磷酸化而阻滞传导,抑制肿瘤细胞的增殖,从而实现靶向治疗。
易瑞沙是由英国阿斯利康制药研发
国内买2万的特罗凯,印度卖1300元
2018-04-16众所周知,在治疗肺癌的过程中,特罗凯成了必选药品,尤其是晚期肺癌患者。而患者最为关心的就是价格,印度特罗凯售价与原厂的罗氏特罗凯价格不仅仅是几倍,而是十几倍。
检查EGFR在服用特罗凯更保险
2018-04-16特罗凯在治疗晚期肺癌上疗效是最为显着的,所以很多的患者一检查出患上了肺癌,立即选择服用特罗凯,盲吃特罗凯在国内50%的受用几率。
但是一般是不建议在没有基因突
乳腺癌的药物琳琅满目,最有效的还是依西美坦
2018-04-16国内乳腺癌目前还是依托着手术治疗,而且对于无法手术的都是采用了化疗的手法,目前乳腺癌的新药层出不穷,让我们眼花缭乱但是新药依西美坦缺水赢得了广大患者的一直信赖。
国内依西美坦的最新价位是多少?
2018-04-16乳腺癌目前是我们的大敌,而国内都是采用手术或者是化疗的手段来控制病情,而除此之外还是需要其他的治疗手段来治疗,而依西美坦就是一款非常有疗效的乳腺癌药物。那么价格
直肠癌的最佳处理标准:希罗达联合治疗
2018-04-16直肠癌目前已经成为了第三大常见肿瘤,而且在世界范围内也是非常受到瞩目,在中国每年直肠癌的发病速度一直在激增,领先于全国,希罗达作为直肠癌的克星,一直深受关注,下面我们
希罗达在中国上市了吗?
2018-04-16希罗达作为一款非常有效的乳腺癌药物,疗效非常好,受到患者的一致认可,而且在市面上已经经历过很多的临床认证,确实是非常具有实力的一款药物,那么希罗达在中国上市了吗?可以
口服希罗达有哪些好处?
2018-04-16提到希罗达,我们就想到了这是一款治疗乳腺癌的神药,而且疗效惊人,而国内都是采用手术或者化疗,但是为何希罗达就这么有优势,主要还是有其原因。
国内患者很多数有的注
XL184卡博替尼:强过舒尼替尼的肾癌一线用药
2018-04-16XL184卡博替尼是拥有九个靶点的抗癌药,在治疗多种癌症上面发挥出色,尤其是在肾癌的治疗过程中,能够强过舒尼替尼,成为肾癌的一线用药。
其中最新的一项研究表明184在
卡博替尼184与特罗凯联合用药效果惊人
2018-04-16在晚期治疗肺癌的过程中,更多的人选择的是靶向药,尤其是特罗凯应用的非常广泛,特罗凯主要针对的是EGFR基因突变的,患者,那对于EGFR不突变的非小肺癌患者来说,没有靶向药用,难
卡博替尼184肿瘤控制率接近100%
2018-04-16肺癌是目前国内第一大癌症,除了发病率比较高的EGFR基因型,还有另外一种,就是RET基因的重排,这部分的患者,可以使用卡博替尼184来治疗。
在非小细胞肺癌患者中,大概有1%
1957元一瓶的希罗达哪里购得?
2018-04-16长期以来,乳腺癌一直困扰着我们,而且国内在治疗方面确实存在很多的缺陷,化疗带来的身体不耐受性,而希罗达作为最新型的口服抗癌药发挥了非常好的优势,为我们带来了非常不错
托瑞米芬在中国上市了吗?
2018-04-16我们了解到目前乳腺癌已经成为了女性的大敌,而且近几年来乳腺癌新药一直层出不穷,但是很多患者双眼已经花了,而托瑞米芬是一款非常不错的乳腺癌药物,而且在2013年就已经上
托瑞米芬:乳腺癌内分泌治疗的先锋军
2018-04-16目前乳腺癌的发病率一直呈现极恶的趋势,而且乳腺癌的发病率一直居高不下,发病年龄也是趋于年轻化,而托瑞米芬确实带给了我们很大的信念。那么到底托瑞米芬疗效如何呢?
国内托瑞米芬的最新价格?
2018-04-16随着国内每年乳腺癌患者人数的日益上升,死亡率也是久高不下,因此防治和治疗乳腺癌目前已经成为了医学界的重点,而托瑞米芬作为提高患者的机体免疫力,价格怎样呢?
托
氟维司群是单用药还是联合为好呢?
2018-04-16氟维司群注射液对于很多患者非常陌生,但是对于乳腺癌患者还是非常熟悉的,癌症患者的治疗目前往往需要联合才会有很好的效果,那么氟维司群是单用药还是联合为好呢?
3000多的依维莫司去哪里购买?
2018-04-16随着社会的不断前进,医学领域的新药层出不穷,而且种类和作用也是各种各样,说明这时代在不断的发展,那么听说印度依维莫司受到很多患者的青睐。
我们了解到依维莫司是
为何印度赫赛汀仅售5750元一瓶呢?
2018-04-16赫赛汀是晚期乳腺癌的救命稻草,而且在中国上市的几十年间确实是造福了很多的患者,临床应用非常广泛,赫赛汀因此受到了很大的关注度,对于癌症患者来讲,赫赛汀能够达到质优价
吃帕唑帕尼肺癌好了真假?
2018-04-16帕唑帕尼是一种酪氨酸激酶抑制剂适用于为治疗晚期肾细胞癌患者。同时治疗软组织肉瘤、上皮性卵巢癌和非小细胞肺癌和一些恶性血液病等的治疗。
帕唑帕尼对于治疗
赫赛汀针对心功能不全者如何应答?
2018-04-16说到赫赛汀,我们了解到这是一款非常有效的乳腺癌药物,而且罹患乳腺癌大的患者中约%20-30%的HER2阳性乳癌患者,所以这样看来人群非常之广,给了我们更多的期望,那么心功能不全
乐伐替尼Lenvatinib完爆多吉美的抗肝癌靶向药
2018-04-16乐伐替尼Lenvatinib是由日本卫材公司研发的药品,是属于靶向药中的一种,在治疗肝癌的过程中发挥到了极致,而且有人表示乐伐替尼Lenvatinib完爆多吉美的抗肝癌靶向药。
赫赛汀是化疗药物吗?疗效如何?
2018-04-16可能很多人知道赫赛汀是乳腺癌的良药,而且确实是非常受欢迎,已经成功的应用到了患者的实际生活中,赫赛汀能显著改善患者的生存质量,而且减少复发的风险,延长患者的生存期限
吃赫赛汀四点需要铭记!
2018-04-16赫赛汀作为一款非常有效的乳腺癌药物,适用于HER2 过度表达的转移性乳腺癌。而且疗效非常的神奇,这也意味着HER2+乳腺癌更具有侵袭性,而且能有效的抑制癌细胞的增值和生长,